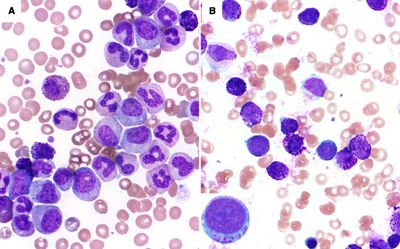
Mutational analysis in BCR-ABL1 positive leukemia by deep sequencing based on nanopore MinION technology

Mutational analysis in BCR-ABL1 positive leukemia by deep sequencing based on nanopore MinION technology
- shared.published_on: June 27 2017
- shared.source: Experimental and Molecular Pathology
We report a third-generation sequencing assay on nanopore technology (MinION) for detecting BCR-ABL1 KD mutations and compare the results to a Sanger sequencing(SS)-based test in 24 Philadelphia-positive (Ph +) leukemia cases. Our data indicates that MinION is markedly superior to SS in terms of sensitivity, costs and timesaving, and has the added advantage of determining the clonal configuration of multiple mutations. We demonstrate that MinION is suitable for employment in the hematology laboratory for detecting BCR-ABL1 KD mutation in Ph + leukemias.